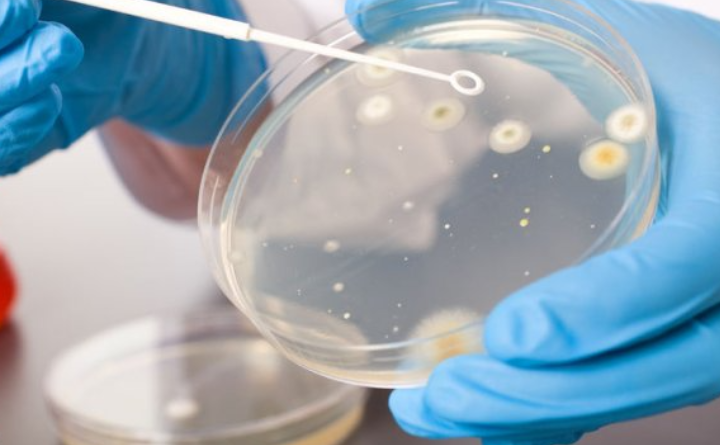

细胞培养中血清能起到什么作用?
血清主要作用:提供基本营养物质:氨基酸、维生素、无机物、脂类物质、核酸衍生物等,是细胞生长必须的物质。
提供激素和各种生长因子:胰岛素、肾上腺皮质激素(氢化可*松、地塞米松)、类固醇激素(雌二醇、睾酮、孕酮)等。生长因子如成纤维细胞生长因子、表皮生长因子、血小板生长因子等。
提供结合蛋白:结合蛋白作用是携带重要地低分子量物质,如白蛋白携带维生素、脂肪、以及激素等,转铁蛋白携带铁。结合蛋白在细胞代谢过程中起重要作用。
提供促接触和伸展因子使细胞贴壁免受机械损伤。
对培养中的细胞起到某些保护作用:有一些细胞,如内皮细胞、骨髓样细胞可以释放蛋白酶,血清中含有抗蛋白酶成分,起到中和作用。这种作用是偶然发现的,现在则有目的的使用血清来终止胰蛋白酶的消化作用。因为胰蛋白酶已经被广泛用于贴壁细胞的消化传代。血清蛋白形成了血清的粘度,可以保护细胞免受机械损伤,特别是在悬浮培养搅拌时,粘度起到重要作用。血清还含有一些微量元素和离子,他们在代谢解毒中起重要作用,如SeO3,硒等。
细胞培养基既是培养细胞中供给细胞营养和促使细胞生殖增殖的基础物质,也是培养细胞生长和繁殖的生存环境。
细胞培养基的成份基本介绍
动物血清成分复杂,各种生物大小分子混合在一起,有些成分至今尚未搞清楚。血清对细胞生长很有效,但后期对培养产物的分离、提纯以及检测造会成一定困难。另外高质量的动物血清来源有限,成本高,限制了它的大量使用。
常用的动物血清主要有牛血清和马血清。牛血清分为胎牛血清和犊牛血清,前者来源少,价格高;后者要求刚产下尚未哺乳的小牛,因为哺乳后的小牛血清中可能含有更复杂的成分。血清中已知的成分主要有蛋白质、氨基酸、葡萄糖、激素等。蛋白质主要是白蛋白和球蛋白。
水解乳蛋白、胶原是另外两种较好的天然培养基成分。水解乳蛋白是乳白蛋白的水解产物,呈蛋黄色粉末状,富含氨基酸。一般配制成0.5%溶液,微酸性。胶原是从动物真皮中提取的,具改善细胞表面特性促使其附着生长的作用。
氨基酸是细胞合成蛋白质的基本成分,氨基酸中有12种是细胞本身不合成的,必须由培养液提供。激素有胰岛素、生长激素和多种生长因子如表皮生长因子、成纤维细胞生长因子、增殖刺激因子(MSA)、类胰岛素生长因子(IGFl、IGF2)等。
咨询
- 438
- 点赞
- 复制链接
- 举报